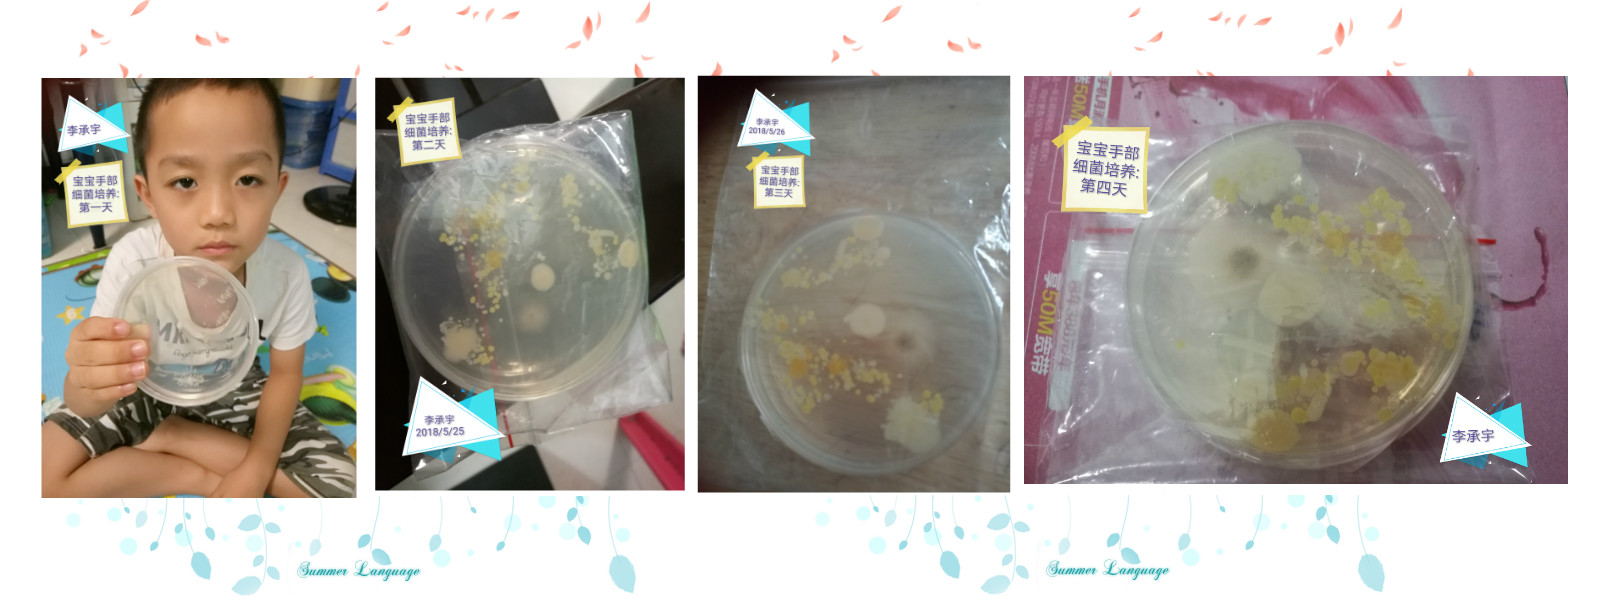

《小细菌 大世界(布朗海口国际园)》
前些天,布朗幼儿园海口国际园奥维班来了一位新老师,她是李子墨小朋友的妈妈,同时也是海南医学院―香港大学热带传染病联合实验室的一名博士。她要给小朋友上一堂细菌微生物课,告诉小朋友们知道细菌长什么样子、在什么情况下细菌会快速的生长、如何预防细菌进入人的身体以及如何近距离观察细菌,目的是让小朋友们了解细菌的多样性,知道细菌对人体的益处和害处,培养良好的卫生习惯。
我们生活中有许多细菌,那你见过细菌吗?知道它长什么样子吗?它都在哪里呢?带着这些问题,来让博士阿姨给我们答疑解惑吧!

在我们刚出生的时候细菌就跟我们在一起,保护着我们,我们的头发上、皮肤上、手上、肠胃道中有很多细菌,这些都是“好细菌”,是我们的好朋友;但如果我们的手脏了,手上就会有致病的“坏细菌”,吃到肚子里面我们就会生病。小朋友们,快来用专业显微镜认识一下“好细菌”和“坏细菌”的模样吧!




哇!原来在显微镜下细菌的样子这么有趣!有的是粉色的,有的像泡泡,有的像小虫子,有的还在动呢……小朋友们特别兴奋地和好伙伴们讨论自己看到的细菌,感觉非常奇妙!那我们手上的细菌怎样才能看的到呢?博士阿姨拿出了“道具”――细菌培养皿。细菌很小,我们一般用肉眼看不到它,但是通过将我们手上的细菌接种在培养基上,经过几天的时间,细菌在培养基上大量生长成为菌落,我们就能够用肉眼直接看到它们了。

通过每天对细菌不同变化的观察,小朋友们都发现自己手上的细菌原来有那么多;家长们也非常的细心,帮孩子们记录培养基每天的生长变化。

为了我们的身体健康,洗手是日常生活中最简单有效的防病措施,是预防疾病的第一道防线,让我们一起来学习正确的洗手步骤吧!




老师和父母的千叮万嘱,不如通过这样一次真实、可视、活灵活现、亲自体验和感受的活动,让孩子们养成主动洗手的好习惯,再也不用家长和老师催促孩子们洗手了!家长们也对这个课程非常关注,反映很强烈,都赞不绝口呢!这就是润物细无声的教育!最后,再次感谢博士阿姨给孩子们带来精彩的科普盛宴,为孩子们科学认知世界打开了一扇窗!
用心做教育,做儿童心上的教育!
Tel :15611010433